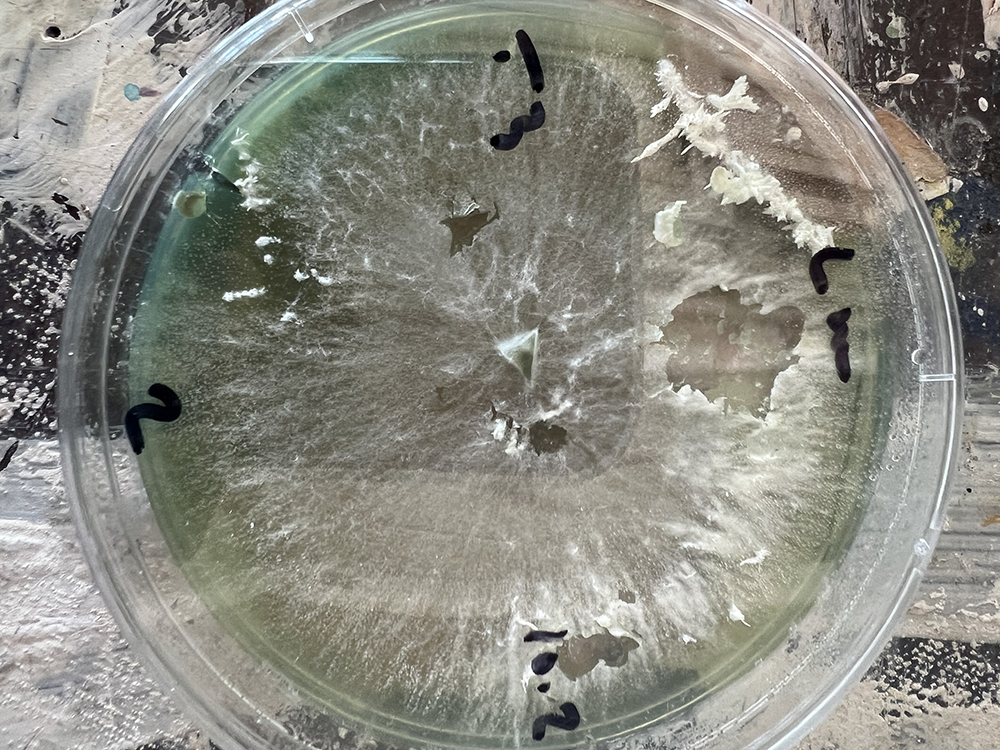

Mushroom Workshop

Art + DIY Mushroom Workshop
When: March 9, 2024
Where: Art Department, UIC, Great Space
Sponsored by Institute of the Humanities and Art
This program is an introductory budget friendly workshop to research and learn about the world of mushrooms. We will focus on how to inoculate mushroom spores with the head mycologist of Windy City Mushrooms - Matthew Lopez - and learn about basic physiology, growth cycle, and at home growing techniques for oyster, lion’s mane, and shiitake cultivation. Serena JV Elston, a Chicago based artist, will talk about her work with mushrooms and how to use them for the arts. March 9, 10 am – 1pm, @ UIC Art and Exhibition Hall, South Peoria Street Chicago, IL 60607
All supplies provided. Family friendly!